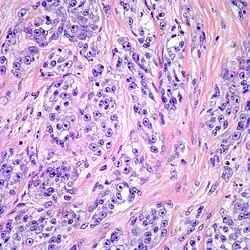

Clear cell sarcoma
| Clear cell sarcoma | |
|---|---|
| Other names | Malignant melanoma of the soft parts |
![]() | |
| Clear cell sarcoma. Tumor cells with prominent nucleoli and clear cytoplasm are arranged in well-defined nests surrounded by dense fibrous stroma. | |
| Specialty | Oncology |
Clear cell sarcoma is a sub-type of a rare form of cancer called a sarcoma.[1] It is known to occur mainly in the soft tissues and dermis. Rare forms were thought to occur in the gastrointestinal tract before they were discovered to be different and redesignated as gastrointestinal neuroectodermal tumors.
Recurrence is common.[2]
Clear cell sarcoma's neoplastic cells express the EWSR1-ATF1 fusion gene in a majority of cases or a EWSR1-CREB1, EWSR1-CREM,[3] or EWSR1-DDIT3[4] fusion gene in a small subset of cases (see FET gene family of fusion genes).
Clear cell sarcoma of the soft tissues in adults is not related to the pediatric tumor known as clear cell sarcoma of the kidney.[5]
Signs and symptoms
It presents as a slow growing mass that especially affects tendons and aponeuroses and it is deeply situated. Patients often perceive it as a lump or hard mass. It causes either pain or tenderness but only until it becomes large enough. This kind of tumor is commonly found in the extremities, especially around the knee, feet and ankle. Patients diagnosed with clear cell sarcoma are usually between the ages of 20 and 40.[1]
Pathology
Despite the name clear cell sarcoma, the tumor cells do not necessarily need to have clear cytoplasm. The lesion has a distinctly nested growth pattern with a mixture of spindle, epithelioid and tumor giant cells. Approximately two thirds of the tumors contain melanin pigment. Clear cell sarcoma, similar to melanoma, has consistent positivity for S-100, HMB-45, and MITF.[6]
Diagnosis
Imaging studies such as X-rays, computed tomography (CT) scans, or MRI may be required to diagnose clear-cell sarcoma together with a physical exam. Normally a biopsy is also necessary. Furthermore, a chest CT, a bone scan, and positron emission tomography (PET) may be part of the tests in order to evaluate areas where metastases occur.[7]
Treatment
Treatment depends upon the site and the extent of the disease. Clear cell sarcoma is usually treated with surgery in the first place in order to remove the tumor. The surgical procedure is then followed by radiation and sometimes chemotherapy.[8] Few cases of clear cell sarcoma respond to chemotherapy.[1] Several types of targeted therapy that may be of benefit to people with clear cell sarcoma are currently under investigation.[1]
Prognosis
When the tumor is large and there is presence of necrosis and local recurrence, the prognosis is poor. Presence of metastasis occurs in more than 50% cases and the common places of its occurrence are the bone, lymph node and lungs.[9][10] Five-year survival rates, which are reported to be between 50 and 65%, can be misleading because the disease is prone to late metastasis or recurrence. Ten and twenty-year survival rates are 33% and 10%, respectively.[1]
See also
- Melanoma
- Clear-cell sarcoma of the kidney
- List of cutaneous conditions
- Hyalinizing clear cell carcinoma - has the same chromosomal translocation
References
- ^ a b c d e Barry, G; Nielsen, T (June 2012). "Clear Cell Sarcoma of Soft Tissue". ESUN. 9 (3). Retrieved 15 June 2012.
- ^ Malchau SS, Hayden J, Hornicek F, Mankin HJ (May 2007). "Clear cell sarcoma of soft tissues". J Surg Oncol. 95 (6): 519–22. doi:10.1002/jso.20730. PMID 17192915. S2CID 27122422.
- ^ Argani P, Harvey I, Nielsen GP, Takano A, Suurmeijer AJ, Voltaggio L, Zhang L, Sung YS, Stenzinger A, Mechtersheimer G, Dickson BC, Antonescu CR (November 2020). "EWSR1/FUS-CREB fusions define a distinctive malignant epithelioid neoplasm with predilection for mesothelial-lined cavities". Modern Pathology. 33 (11): 2233–2243. doi:10.1038/s41379-020-0646-5. PMC 7584759. PMID 32770123.
- ^ Flucke U, van Noesel MM, Siozopoulou V, Creytens D, Tops BB, van Gorp JM, Hiemcke-Jiwa LS (June 2021). "EWSR1-The Most Common Rearranged Gene in Soft Tissue Lesions, Which Also Occurs in Different Bone Lesions: An Updated Review". Diagnostics. 11 (6): 1093. doi:10.3390/diagnostics11061093. PMC 8232650. PMID 34203801.
- ^ Poppe B, Forsyth R, Dhaene K, Speleman F. Soft tissue tumors: Clear cell sarcoma. Atlas Genet Cytogenet Oncol Haematol. November 2002.
- ^ "Clear cell sarcoma". Pathology Outlines. Retrieved 26 May 2015.
- ^ "Diagnosis". Mayo Clinic. Retrieved 2010-06-29.
- ^ "Treatment". Mayo Clinic. Retrieved 2010-06-29.
- ^ "Clear Cell Sarcoma of Tendons and Aponeuroses". Retrieved 2010-06-29.
- ^ Alhatem, Albert (2020). "Primary Cutaneous Clear Cell Sarcoma, Clinical Outcome With Sentinel Lymph Nodes Status". Am J Clin Pathol. 153 (5): 799–810. doi:10.1093/ajcp/aqaa009. PMID 32157275.